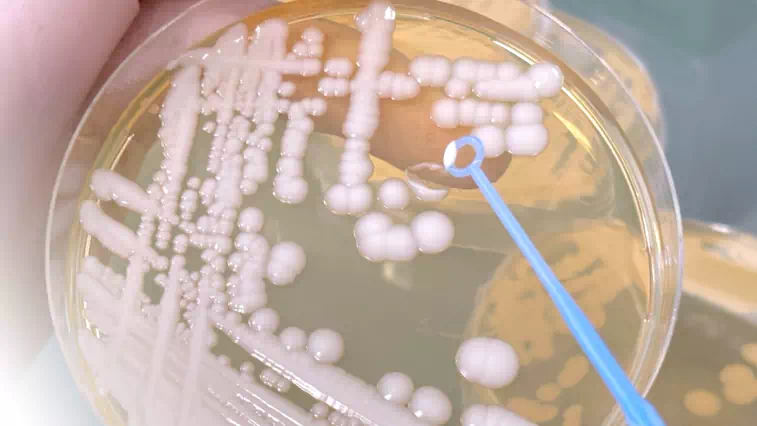
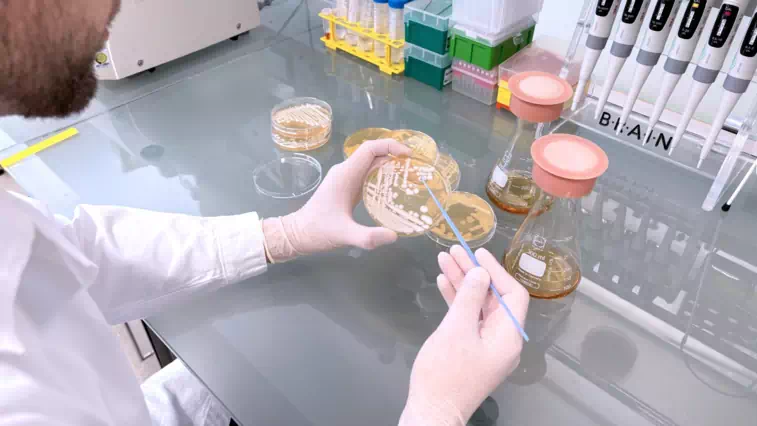

News and Stories from the Zwingenberg R&D Site
20.10.2025
Protecting innovation: Intellectual property management in biotechnology

Business
Show Article
09.10.2025
Methanol-free K. phaffii (P. pastoris) system for scalable, cost-effective industrial protein production
Technology
Show Article
01.09.2025
Novel enzyme discovery via MetXtra: delivering industrial enzyme breakthroughs

Technology
Show Article
26.08.2025
Biotechnology: versatile, colorful, and not just red

Business
Show Article
02.06.2025
Microbial fermentation of industrial side streams offers a pathway to sustainability and innovation

Business
Show Article
19.05.2025
From Pichia to Komagataella: A new name for the same industrial powerhouse
Technology
Show Article
07.05.2025
Seven reasons to use BRAIN Biotech's contract research services

Business
Show Article
10.04.2025
Hands-on perspectives on AI-driven innovation in industrial biotech applications

Business
Show Article
20.03.2025
Driving innovation with public funding

Business
Show Article